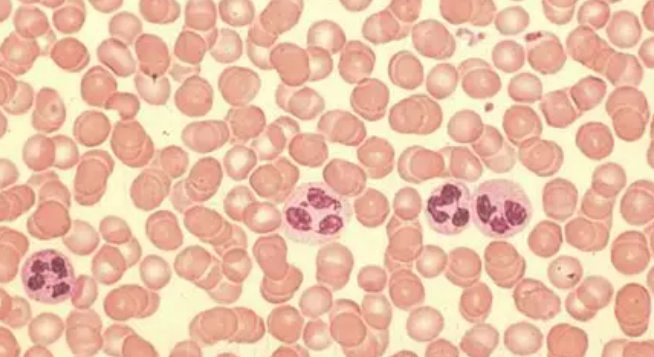
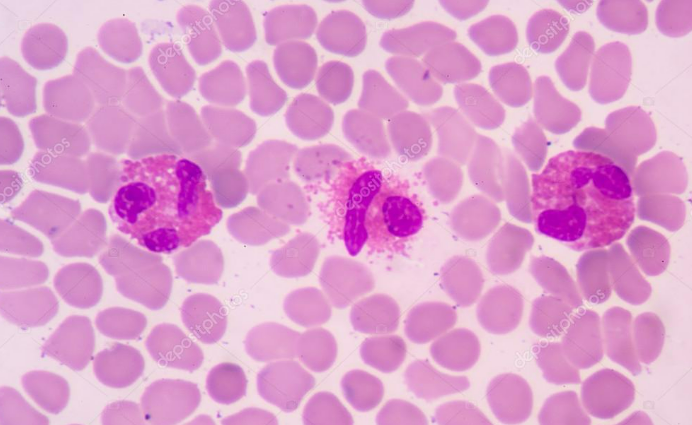

CIE iGCSE Co-ordinated Sciences-B9.4 Blood- Study Notes- New Syllabus
CIE iGCSE Co-ordinated Sciences-Link – Study Notes
CIE iGCSE Co-ordinated Sciences-Link – Study Notes -CIE iGCSE Co-ordinated Sciences – per latest Syllabus.
Key Concepts:
Core
- List the components of blood as: red blood cells, white blood cells, platelets and plasma
- Identify red and white blood cells in photomicrographs and diagrams
- State the functions of the following components of blood:
(a) red blood cells in transporting oxygen, including the role of haemoglobin
(b) white blood cells in phagocytosis and antibody production
(c) platelets in clotting (details are not required)
(d) plasma in the transport of blood cells, ions, nutrients, urea, hormones and carbon dioxide - State the roles of blood clotting as preventing blood loss and the entry of pathogens
Supplement
- Identify lymphocytes and phagocytes in photomicrographs and diagrams
- State the functions of:
(a) lymphocytes – antibody production
(b) phagocytes – engulfing pathogens by phagocytosis
CIE iGCSE Co-Ordinated Sciences-Concise Summary Notes- All Topics
Components of Blood
📌 Introduction
Blood is a connective tissue that transports substances, protects against disease, and helps maintain homeostasis. It is made of cells (RBCs, WBCs, platelets) suspended in a liquid medium (plasma).
1. Red Blood Cells (RBCs / Erythrocytes)
- Structure: Small, biconcave discs (↑ surface area), no nucleus (more space for haemoglobin), flexible to pass through capillaries.
- Function: Transport oxygen (via haemoglobin → oxyhaemoglobin) and small amount of CO₂ (majority in plasma).
2. White Blood Cells (WBCs / Leucocytes)
- Larger than RBCs, fewer in number, have a nucleus.
- Types & Functions:
- Phagocytes: Engulf and digest pathogens (phagocytosis).
- Lymphocytes: Produce antibodies to destroy pathogens.
- Role: Defence against infection.
3. Platelets (Thrombocytes)
- Tiny cell fragments (not complete cells), formed from large bone marrow cells.
- Function: Blood clotting at injury sites, prevent excessive blood loss, barrier against pathogen entry.
4. Plasma
- Pale yellow liquid (~55% of blood).
- Contains: water, nutrients (glucose, amino acids, vitamins, fatty acids), gases (mainly CO₂, some O₂), hormones, excretory products (urea, uric acid), ions (Na⁺, K⁺, Cl⁻, Ca²⁺).
- Functions: Transport medium for cells + substances, maintains blood pH and circulation.
📊 Summary Table
| Component | Structure | Main Function |
|---|---|---|
| RBCs | Biconcave, no nucleus, haemoglobin | Carry oxygen |
| WBCs | Nucleated, fewer, variable shapes | Immunity: phagocytosis + antibodies |
| Platelets | Tiny cell fragments | Clotting → prevent blood loss & infection |
| Plasma | Pale yellow fluid | Transports cells + nutrients + wastes + hormones |
⚡ Quick Recap
Blood has 4 components:
RBCs → oxygen transport (haemoglobin).
WBCs → defence (phagocytes + lymphocytes).
Platelets → clotting (prevent blood loss + infection).
Plasma → transport of dissolved substances.
👉 Mnemonic: “Really Wonderful People Pass” (RBCs, WBCs, Platelets, Plasma).
Identifying Red & White Blood Cells
📌 Introduction
In diagrams and microscope images (photomicrographs), you must be able to spot the difference between RBCs and WBCs. They look very different once you know the key features.
🔴 Red Blood Cells (RBCs / Erythrocytes)
- Appearance in photomicrographs/diagrams:
- Round, biconcave discs (doughnut-like shape).
- No nucleus (clear centre).
- Appear many in number, tightly packed.
- Stain light red/pink in microscope images.
- Key ID trick: Uniform size, pale centre, huge numbers.
⚪ White Blood Cells (WBCs / Leucocytes)
- Appearance in photomicrographs/diagrams:
- Much fewer than RBCs.
- Have a large, stained nucleus (dark purple/blue under stain).
- Irregular in shape (some round, some lobed).
- Larger in size compared to RBCs.
- Key ID trick: Look for darkly stained nucleus and bigger size.
📝 Summary Table
| Feature | RBC (Erythrocyte) | WBC (Leucocyte) |
|---|---|---|
| Shape | Biconcave disc | Irregular/round |
| Nucleus | Absent | Present (large, stained) |
| Size | Smaller | Larger |
| Number | Very many | Few |
| Staining | Light pink/red | Dark purple nucleus |
⚡ Quick Recap
RBC = small, many, no nucleus, pale centre.
WBC = large, few, dark nucleus.
👉 Mnemonic: “Red = Regular, White = With Nucleus”
Functions of Blood Components
📌 Introduction
Blood is a transport medium + defence system. Its components each have specific functions.
(a) Red Blood Cells (RBCs / Erythrocytes)
- Main role → Transport oxygen.
- Contain haemoglobin, a red pigment that binds with oxygen to form oxyhaemoglobin in the lungs.
- Oxyhaemoglobin releases oxygen in tissues where it is needed for respiration.
- Shape = biconcave disc → increases surface area for oxygen exchange.
- No nucleus → more space for haemoglobin.
(b) White Blood Cells (WBCs / Leucocytes)
- Function → Defence against pathogens.
- Two key roles:
- Phagocytosis: some WBCs engulf and digest bacteria/viruses.
- Antibody production: others make proteins (antibodies) that bind to and destroy specific pathogens.
(c) Platelets
- Small fragments of cells.
- Function → Blood clotting.
- Clots prevent excessive bleeding and block entry of pathogens at wound sites.
(d) Plasma
- Liquid part of blood (mainly water).
- Transports:
- Blood cells (RBCs, WBCs, platelets).
- Ions (e.g. salts for osmotic balance).
- Nutrients (e.g. glucose, amino acids).
- Urea (to kidneys for excretion).
- Hormones (to target organs).
- Carbon dioxide (mainly as hydrogen carbonate ions).
📝 Summary Table
| Component | Function |
|---|---|
| RBCs | Carry oxygen using haemoglobin |
| WBCs | Defence → phagocytosis + antibodies |
| Platelets | Clot blood to stop bleeding + block pathogens |
| Plasma | Transport of cells, ions, nutrients, wastes, hormones, CO₂ |
⚡ Quick Recap
RBC → O₂ transport (haemoglobin)
WBC → Defence (phagocytosis + antibodies)
Platelets → Clotting
Plasma → Transport medium
👉 Mnemonic: “Really Wild Pandas Play” = RBC, WBC, Platelets, Plasma
Identifying Lymphocytes & Phagocytes
📌 Introduction
Both are types of white blood cells, but they look quite different under the microscope. Examiners often test whether you can tell them apart.
Lymphocytes
- Size → about same size as a red blood cell.
- Nucleus → very large, round, takes up most of the cell (thin rim of cytoplasm).
- Cytoplasm → narrow layer, appears as a thin blue “halo” around the nucleus.
- Function reminder → produce antibodies for specific defence.
👉 Tip: If the nucleus looks huge and dominates the cell → think “L” for Lymphocyte.
Phagocytes (e.g. neutrophils, macrophages)
- Size → much larger than red blood cells.
- Nucleus → irregular, lobed or kidney-shaped (not smooth and round).
- Cytoplasm → more abundant compared to lymphocytes.
- Function reminder → engulf and digest pathogens by phagocytosis.
👉 Tip: If the nucleus looks wriggly/lobed and there’s plenty of cytoplasm → it’s a Phagocyte.
📝 Comparison Table
| Feature | Lymphocyte | Phagocyte |
|---|---|---|
| Size | Same as RBC | Much larger than RBC |
| Nucleus | Large, round, fills most of cell | Lobed / irregular |
| Cytoplasm | Thin rim only | Large amount |
| Function | Antibody production | Phagocytosis |
⚡ Quick Recap
Lymphocyte → Little cell, Large nucleus
Phagocyte → Plenty of cytoplasm, Funny-shaped nucleus
👉 Mnemonic: “L = Little, P = Plenty”
Functions of Lymphocytes & Phagocytes
(a) Lymphocytes
- Produce antibodies against specific pathogens.
- Antibodies attach to antigens on pathogens → mark them for destruction.
- Provide specific immunity (long-lasting, memory cell formation).
(b) Phagocytes
- Recognise and engulf pathogens (bacteria, viruses, debris).
- Trap the pathogen inside a vesicle → release digestive enzymes.
- Destroy the pathogen by phagocytosis.
- Provide non-specific defence (act against any pathogen).
⚡ Quick Recap
Lymphocytes → make antibodies (specific defence)
Phagocytes → eat pathogens (non-specific defence)
👉 Mnemonic: “L = Learn & target, P = Pac-Man eat”
Roles of Blood Clotting
1. Preventing Blood Loss
- When a blood vessel is cut, platelets gather at the site.
- They release chemicals → trigger clotting cascade.
- A fibrin mesh forms, trapping blood cells → creates a clot (scab).
- This seals the wound and stops further blood loss.
2. Preventing Entry of Pathogens
- The clot acts as a protective barrier over the wound.
- Stops bacteria, viruses, and other pathogens from entering the body.
- Reduces risk of infection.
⚡ Quick Recap
Main roles of clotting:
✔️ Stops bleeding (blood loss)
✔️ Blocks germs (pathogen entry)
👉 Mnemonic: Clot = Cover + Close
